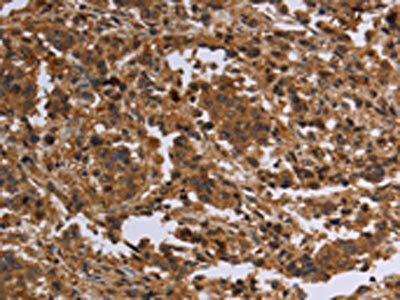

-
中文名稱:FLG兔多克隆抗體
-
貨號:CSB-PA247101
-
規格:¥1100
-
圖片:
-
The image on the left is immunohistochemistry of paraffin-embedded Human cervical cancer tissue using CSB-PA247101(FLG Antibody) at dilution 1/20, on the right is treated with synthetic peptide. (Original magnification: ×200)
-
The image on the left is immunohistochemistry of paraffin-embedded Human liver cancer tissue using CSB-PA247101(FLG Antibody) at dilution 1/20, on the right is treated with synthetic peptide. (Original magnification: ×200)
-
-
其他:
產品詳情
-
Uniprot No.:
-
基因名:
-
別名:ATOD2 antibody; Epidermal filaggrin antibody; FILA_HUMAN antibody; Filaggrin antibody; Filaggrin precursor antibody; Fillagrin antibody; FLG antibody; Profilaggrin antibody
-
宿主:Rabbit
-
反應種屬:Human
-
免疫原:Synthetic peptide of Human FLG
-
免疫原種屬:Homo sapiens (Human)
-
標記方式:Non-conjugated
-
抗體亞型:IgG
-
純化方式:Antigen affinity purification
-
濃度:It differs from different batches. Please contact us to confirm it.
-
保存緩沖液:-20°C, pH7.4 PBS, 0.05% NaN3, 40% Glycerol
-
產品提供形式:Liquid
-
應用范圍:ELISA,IHC
-
推薦稀釋比:
Application Recommended Dilution ELISA 1:1000-1:2000 IHC 1:25-1:100 -
Protocols:
-
儲存條件:Upon receipt, store at -20°C or -80°C. Avoid repeated freeze.
-
貨期:Basically, we can dispatch the products out in 1-3 working days after receiving your orders. Delivery time maybe differs from different purchasing way or location, please kindly consult your local distributors for specific delivery time.
-
用途:For Research Use Only. Not for use in diagnostic or therapeutic procedures.
相關產品
靶點詳情
-
功能:Aggregates keratin intermediate filaments and promotes disulfide-bond formation among the intermediate filaments during terminal differentiation of mammalian epidermis.
-
基因功能參考文獻:
- The present study demonstrated that the downregulation of filaggrin in the epidermis by toluene is mediated by ERK1/2 and STAT3-dependent pathways. PMID: 27498358
- FLG mutation was not associated with MM in the studied populations. PMID: 28833578
- The results show that patients carrying filaggrin mutations had increase prevalence of Staphylococcus aureus colonization. PMID: 28317091
- We suggest that SNP in FLG (rs11204981) may serve as an important predictive marker for the combined eczema plus asthma phenotype, and that the highest level of expression in heterozygous may have a protective role in developing allergy phenotype. PMID: 29569866
- This study indicates an increased susceptibility to actinic keratosis in individuals with homozygous, but not heterozygous, FLG mutations and in patients with atopic dermatitis compared to psoriasis. PMID: 28213896
- This study demonstrated, for the first time, that FLG expression in UCB is associated with eczema development in infancy. Moreover, our analysis provided prediction models that were capable of discriminating, to a great extent, between those who will and will not develop eczema in infancy. PMID: 28502108
- In a side-to-side comparison of two different methods to determine NMF in atopic dermatitis patients: Raman microspectroscopy and stratum corneum tape stripping followed by HPLC. both methods demonstrated a concentration-depth dependence of NMF and reduced NMF levels in the carriers of filaggrin null mutations PMID: 27805415
- FLG and POSTN expression may be downregulated and upregulated, respectively, in the esophageal mucosa of patients with active eosinophilic esophagitis, and these changes may be restored with treatment in a significant percentage of cases. PMID: 28644349
- immunoreactivity for filaggrin was significantly more intense in the oral mucosa in the patients with OLP/OLL compared with healthy controls PMID: 28000306
- atopic dermatitis patients without palmoplantar hyperlinearity unlikely to carry FLG mutations PMID: 27120251
- FLG mutations are strongly associated with atopic eczema and confer a significant risk of allergic sensitization and asthma in the context of eczema in Polish children. PMID: 29068602
- There was no association of the atopy risk variants in the FLG gene with OFG. PMID: 27306066
- suggest that FLG P478S is a kind of disease modifier which affects serologic parameters such as EDN and ECP PMID: 29281699
- In this study of 97 174 individuals from the Danish general population, FLG loss-of-function mutations were associated with increased ischemic stroke risk PMID: 28164424
- study found that among patients with atopic dermatitis (AD), common FLG null mutations are associated with earlier AD onset in a dose-dependent manner, whereas TSLP rs1898671 appears unrelated to the timing of AD onset PMID: 28479194
- The two SNPs K4671X and rs3126085 of FLG were related to Epstein-Barr virus (EBV)-associated gastric carcinoma. PMID: 28455573
- FLG mutation is associated with IgE sensitization to peanut but not to other allergens in Swedish children up to 16 years of age PMID: 28456621
- Erythemal doses of ultraviolet B exert acute effects on profilaggrin mRNA and filaggrin protein in human skin in vivo. PMID: 28358172
- FLG mutations are associated with early onset of atopic dermatitis, more severe clinical course of disease, and a significantly increased risk ofMolluscum contagiosum sustained skin infection PMID: 28866311
- Study conducted in Croatia found a low frequency of FLG null-mutations in general population (2.6%) and did not confirm FLG null-mutations as an etiological factor for Atopy and Atopic disease in the studied population. PMID: 29087092
- women with FLG mutations may have an increased risk of AD flares during pregnancy and of enduring postpartum problems attributable to perineal trauma during delivery. PMID: 26835886
- FLG mutations are risk factors for atopic dermatitis in Finns, but disease severity and treatment response were independent of patient FLG status. PMID: 27840886
- Patients with both atopic dermatitis and common filaggrin gene mutations are more frequently affected by reduced health-related quality of life PMID: 27995642
- Multiple lines of evidence suggest that FLG genetic variation, have little or no effect on fitness in modern humans. Haplotype-level analysis revealed a recent selective sweep which increased the allele frequency of the Huxian haplogroup in Asian populations. PMID: 27678121
- FLG mutations lead to alterations in epidermal eicosanoid metabolism in atopic dermatitis patients PMID: 27793761
- Filaggrin gene mutations are risk factors for the presence and persistence of atopic dermatitis and explain the discordance of atopic dermatitis within dizygotic twin pairs. PMID: 27653621
- Variations in FLG and TSLP genotype were associated with differences in self-reported skin clearance, TCI usage, and steroid usage. PMID: 27902816
- We show that subjects with FLG-null mutations have more mature Langerhans cells in nonlesional skin irrespective of whether they have AD. PMID: 26934939
- we have proposed that this latitude-dependent gradient of FLG mutations across Europe, Asia and Africa could have provided an evolutionary advantage for heterozygous FLG mutation carriers, residing at northern latitudes, depletion of the FLG downstream product, trans-urocanic acid, would facilitate the intracutaneous synthesis of vitamin D3 by allowing increased transcutaneous absorption of UVB photons PMID: 28338939
- The results of the present study demonstrate that filaggrin knockdown inhibits NHEK migration, adhesion and proliferation, promotes apoptosis and disturbs cell cycle progression. PMID: 27485743
- FLG rs2065955 polymorphism was significantly related to gastric carcinoma. PMID: 27535066
- Four FLG null mutations (3321delA, K4022X, S3296X, and S2889X) were identified in Korean patients with Atopic Dermatitis PMID: 28120571
- IL-33, which is a representative Th2 cytokine, affect as a crucial factor of skin barrier dysfunction by reducing FLG expression in human keratinocytes. PMID: 26867960
- The authors data reveals that the CNV of FLG is associated with AD development in Koreans. PMID: 26554544
- Filaggrin Gene Mutation c.3321delA is Associated with Dry Phenotypes of Atopic Dermatitis in the Chinese Han Population PMID: 27270549
- A mutation p.Y1767X, was related to early onset and severe symptoms, which last until adulthood, and severe atopic dermatitis with other atopic diseases, such as asthma. PMID: 27366014
- The present study examined the possible relationship between SNPs of FLG and chronic idiopathic urticaria (CIU) for the first time, and demonstrated that none of five investigated SNPs (rs2485518, rs3126065, rs2786680, rs3814300, and rs3814299) are correlated with CIU in an Iranian population. PMID: 26796858
- The study revealed 66 FLG mutation carriers and demonstrated an association between c.2282del4 deletion and atopic dermatitis development in Russians and Tatars of Volga-Ural region of Russia. PMID: 27363669
- The levels of filaggrin, inflammatory T helper 2 polarizing cytokines (thymic stromal lymphopoietin (TSLP) and interleukin 33 (IL-33)) and chemokine (C-C motif) ligand 27 (CCL27), histological severity markers, T and dendritic cell counts in biopsies from lesional skin of severe atopic dermatitis patients with and without filaggrin mutation and healthy skin were quantified. No significant differences were found. PMID: 26536977
- The imbalance between Th1 and Th2 polarized immune response seems to extend to Filaggrin homeostasis, through the network of Filaggrin processing enzymes. PMID: 26831231
- Levels of FLG, FLG2 and SPRR3 mRNAs and proteins were reduced in AD skin. PMID: 27304082
- Data suggest that the c.1360A>G (p.T454A) and c.10363G>T (p.D3455Y) mutations of the filaggrin (FLG) gene may lead to alteration of the structure and function of the FLG protein and cause ichthyosis vulgaris in the two families. PMID: 27577213
- genotype-phenotype correlation not obvious in Korean atopic dermatitis patients with null mutations PMID: 25997159
- Results show a strong association of FLG loss-of-function mutations was found with doctor-diagnosed CD and to a lesser extent also with self-reported CD, but not with respiratory symptoms or atopy. PMID: 26451970
- Identify acefylline as an activator of peptidylarginine deiminase 1 and 3 in the epidermis, resulting in filaggrin deimination. PMID: 26616205
- FLG has been, and still remains the major susceptibility gene in patients with AD. PMID: 25580797
- Letter: Knockdown of either filaggrin or loricrin increases the productions of interleukin (IL)-1alpha, IL-8, IL-18 and granulocyte macrophage colony-stimulating factor in stratified human keratinocytes. PMID: 26381575
- Supplementation with the PPARalpha agonist WY14643 improved the homeostasis and barrier function of filaggrin deficient skin models by normalization of the free fatty acid profile. PMID: 26472199
- Filaggrin genotype does not determine the skin's threshold to UV-induced erythema. PMID: 26830116
- In Iranian patients, this study demonstrated that there was no significant association between polymorphisms of FLG gene variants and AD. PMID: 25230061
顯示更多
收起更多
-
相關疾病:Ichthyosis vulgaris (VI); Dermatitis atopic 2 (ATOD2)
-
亞細胞定位:Cytoplasmic granule.
-
蛋白家族:S100-fused protein family
-
組織特異性:Expressed in skin, thymus, stomach, tonsils, testis, placenta, kidney, pancreas, mammary gland, bladder, thyroid, salivary gland and trachea, but not detected in heart, brain, liver, lung, bone marrow, small intestine, spleen, prostate, colon, or adrenal
-
數據庫鏈接:
Most popular with customers
-
-
YWHAB Recombinant Monoclonal Antibody
Applications: ELISA, WB, IHC, IF, FC
Species Reactivity: Human, Mouse, Rat
-
Phospho-YAP1 (S127) Recombinant Monoclonal Antibody
Applications: ELISA, WB, IHC
Species Reactivity: Human
-
-
-
-
-